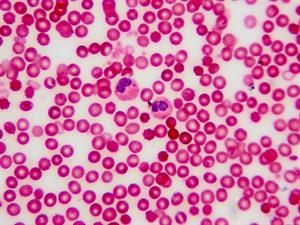
shutterstock_1421837909.jpg

Šūna ir vismazākā dzīvā daļiņa, no kā sastāv organisms.
Šūnām piemīt visas dzīvības pazīmes un tās spēj darboties patstāvīgi.
Svarīgi!
Visas šūnas nav vienādas, tās atšķiras ar savu formu, krāsu, izvietojumu un uzbūvi.
Atšķiras augu un dzīvnieku šūnas, jo tām ir dažādas uzbūves īpatnības, par kurām sīkāk tiks mācīts bioloģijā.

Šīs šūna atšķiras, piemēram, pēc krāsas, jo augu šūnā ir hloroplasti, kuri ietekmē augu zaļo krāsu. Apskatot mikroskopā var redzēt, ka augu šūnai ir apvalks, kaut kas līdzīgs kā kokam ir miza apkārt stumbram, bet dzīvnieku šūnai tāda nav.

Greifrūta šūnas virsma mikroskopā

Augu lapas virsma mikroskopā
Arī cilvēka organisms sastāv no ļoti daudzām šūnām un katrā orgānā pārsvarā ir kāda noteikta veida šūnas. Cilvēka organisms ir daudzšūnu organisms, jo sastāv no ļoti daudzām šūnām.

Cilvēka šūnas
Šūnas organismā ir savstarpēji saistītas un funkcionē saskaņoti. Tajās notiek ķīmiskie procesi, kas ir svarīgi gan šūnas dzīvības uzturēšanai, gan dažādu organisma funkciju nodrošināšanai.

Cilvēka ādas šūnas mikroskopā
Cilvēka asins šūnas - eritrocīti mikroskopā
Vienkāršus organismus, kuriem nav orgānu sauc par baktērijām. Tās ir vienšūnas mikroorganismi.
